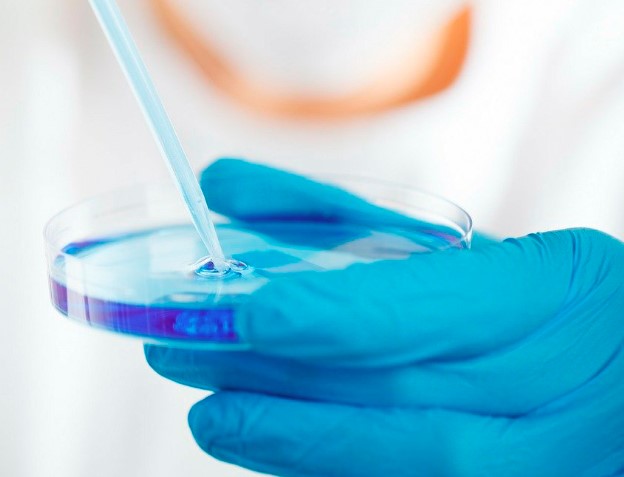
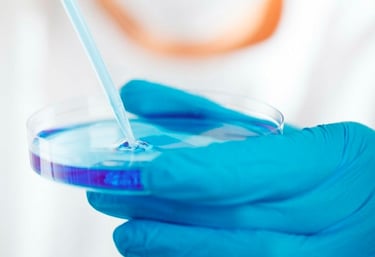

Tratamentos Oferecidos
Método de diagnóstico por meio de ressonância magnética com base na medicina quântica. Essa técnica permite avaliar danos e desequilíbrios físicos, bioquímicos e emocionais.
Biorressonância Magnética Quântica


Ortomolecular/Suplementação
A terapia ortomolecular envolve a correção de desequilíbrios químicos no corpo por meio da suplementação de nutrientes e vitaminas. Isso pode resultar no aumento da energia e vitalidade.




A terapia Reiki é um método de cura complementar que utiliza a transferência de energia para equilibrar o corpo e mente baseada na canalização de energia.
Método de diagnóstico por meio de ressonância magnética com base na medicina quântica. Essa técnica permite avaliar danos e desequilíbrios físicos, bioquímicos e emocionais.
Terapia Reiki
Análise de Exames Laboratoriais
A Análise de Exames Laboratoriais na Terapia Bioquímica
A análise de exames laboratoriais é uma ferramenta poderosa na terapia bioquímica, permitindo identificar desequilíbrios e direcionar o tratamento. Como terapeuta bioquímico, uso essa análise como um complemento essencial aos meus tratamentos, personalizando abordagens terapêuticas específicas e buscando a raiz dos problemas.
Com a análise de exames laboratoriais, posso identificar deficiências nutricionais, desequilíbrios hormonais e muito mais, proporcionando um tratamento personalizado e eficaz. Agende uma consulta e descubra como a terapia bioquímica aliada à análise de exames pode transformar sua saúde e bem-estar.

D I F E R E N C I A L
FAQ
O que é terapia?
É um tratamento holístico e personalizado.
Como funciona a biorressonância?
Ela mapeia desequilíbrios energéticos no corpo.
Quais serviços são oferecidos?
Oferecemos terapia ortomolecular, reiki e análises.
Junior Luiz Schirmer Antunes, farmacêutico bioquímico.
Quem é o profissional?
Qual o objetivo da terapia?
Promover bem-estar físico, mental e emocional.
Avaliações
Veja o que nossos clientes dizem
A terapia quântica transformou minha saúde e bem-estar!
Ana
Chapecó
Os tratamentos são incríveis e realmente fazem a diferença na vida.
Carlos
Chapecó
★★★★★
★★★★★

SIGA-NOS
FALE CONOSCO
Telefone
terapeura.bio.junior@gmail.com
(49) 9 8851-1665
© 2024. Todos os Direitos Reservados


ENDEREÇO
